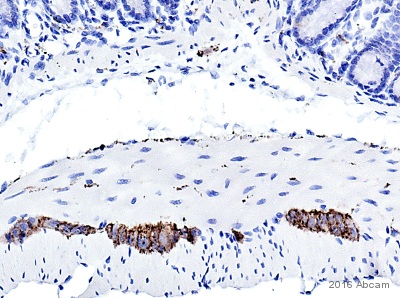

新入荷
再入荷
【NEW限定品】 エーモン/[1854]RGBカラーLEDコントローラー/製品詳細ページ パーツ
 タイムセール
タイムセール
終了まで
00
00
00
999円以上お買上げで送料無料(※)
999円以上お買上げで代引き手数料無料
999円以上お買上げで代引き手数料無料
通販と店舗では販売価格や税表示が異なる場合がございます。また店頭ではすでに品切れの場合もございます。予めご了承ください。
商品詳細情報
| 管理番号 |
新品 :67680167333
中古 :67680167333-1 |
メーカー | 14549371ad | 発売日 | 2025-06-04 23:09 | 定価 | 6000円 | ||
|---|---|---|---|---|---|---|---|---|---|
| カテゴリ | |||||||||
【NEW限定品】 エーモン/[1854]RGBカラーLEDコントローラー/製品詳細ページ パーツ
![エーモン/[1854]RGBカラーLEDコントローラー/製品詳細ページ エーモン/[1854]RGBカラーLEDコントローラー/製品詳細ページ](https://www.amon.jp/upload/save_image/1854_SUB2_L.jpg) エーモン/[1854]RGBカラーLEDコントローラー/製品詳細ページ,
エーモン/[1854]RGBカラーLEDコントローラー/製品詳細ページ, DELTA DESIGN 1670345-50 256K/512K/1MEG SRAM MEMORY PCB BOARD,
DELTA DESIGN 1670345-50 256K/512K/1MEG SRAM MEMORY PCB BOARD, ササフラス・ポストオーバーオールズ・ラリースミス・セント,
ササフラス・ポストオーバーオールズ・ラリースミス・セント, シュランケンカーフ ラウンドファスナー 二つ折財布 バイカラー,
シュランケンカーフ ラウンドファスナー 二つ折財布 バイカラー, Anti-alpha-synuclein aggregate antibody [MJFR-14-6-4-2
Anti-alpha-synuclein aggregate antibody [MJFR-14-6-4-2NGK レーシングプラグ R4118S-9 (3245) 4本 レーシングカート
岩船産 コシヒカリ 3kg 令和6年度産



![【NEW限定品】 エーモン/[1854]RGBカラーLEDコントローラー/製品詳細ページ パーツ](https://www.suruga-ya.jp/database/images/no_photo.jpg)























